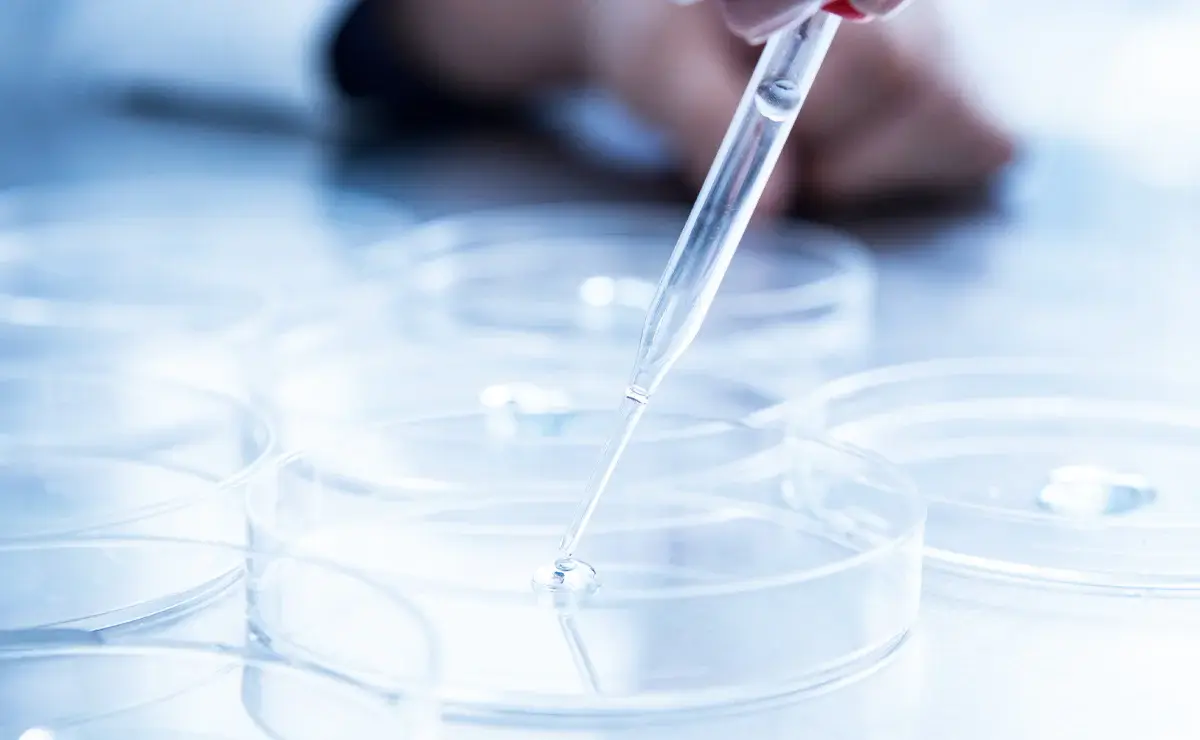

staff スタッフの声
天が領けてくれた水、ミネラルウォーター「日田天領水」を
皆様に安全にお届けすることは私たちの使命です。


continuous
monitoring
連続モニタリング
お客様へ安全で安心なミネラルウォーター「日田天領水」を
真心込めてお届けいたします。
日田天領水は採水から充填・包装に至るまで、一切人の手に触れることなく製品化されていきます。殺菌室にある測定機器で水温やPHの測定を行い、製造ラインに設置されている外観検査機による連続モニタリングで「賞味期限の印字位置」「ラベルの位置」等を検査しています。
最新の工場設備により、僅かな異常も見逃すことはありません。

連続モニタリング装置による監視

製造ラインを走る日田天領水


multiple check 多重チェック体制
最新の手法と五感による評価を用い
日田天領水を検査しています。
製品は一定時間ごとに抜き取り製品規格検査を行っています。この検査では連続モニタリングを行っている検査項目だけではなく、製品の無菌性を保証するための各種細菌検査や、品質を保証する理化学検査、従業員のほぼ全員による試飲が行われます。
細菌検査

目視による異物チェック
Delivering 日田天領水のお届け
「安全・安心」な日田天領水を全国のお客様へお届けします。
最近は日田天領水製品をお取扱いいただいているお店が増えてきたため、そちらでご購入される方も増えてきましたが、日田天領水製品は日田天領水から直接お客様にお送りしております。日田天領水製品の受付は「販売店」様の店舗やWEBなどでも行っています。
注文窓口は異なりますが商品の発送については日田天領水本社を経由しています。販売店様には独自のサービスや情報提供などを行っているところもあり、お客様が自由に注文窓口を選べるのも日田天領水の特徴の一つとなっています。
安全性へのこだわり
view more


